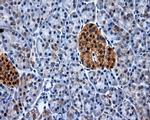
XRCC1 Antibody in Immunohistochemistry (Paraffin) (IHC (P))
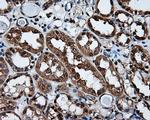
XRCC1 Antibody in Immunohistochemistry (Paraffin) (IHC (P))

Search
OriGene
XRCC1 Monoclonal Antibody (OTI2D8), TrueMAB™
{{$productOrderCtrl.translations['antibody.pdp.commerceCard.promotion.promotions']}}
{{$productOrderCtrl.translations['antibody.pdp.commerceCard.promotion.viewpromo']}}
{{$productOrderCtrl.translations['antibody.pdp.commerceCard.promotion.promocode']}}: {{promo.promoCode}} {{promo.promoTitle}} {{promo.promoDescription}}. {{$productOrderCtrl.translations['antibody.pdp.commerceCard.promotion.learnmore']}}
产品信息
TA500886
种属反应
宿主/亚型
分类
类型
克隆号
抗原
偶联物
形式
浓度
规格
纯化类型
保存液
内含物
保存条件
运输条件
靶标信息
XRCC1 (X-ray cross complementing factor-1) is involved in DNA base excision repair. XRCC1 is a 70 kDa protein that has been shown to be physically associated with other DNA repair enzymes, including poly (ADP-ribose) polymerase (PARP), DNA Ligase III and DNA polymerase beta. XRCC1 contains a BRCT domain (for BRCA1 carboxyl terminus) which was originally found in the tumor suppressor protein BRCA1. Recently, the BRCT domain has been shown to mediate the protein-protein interaction of XRCC1 and DNA ligase III-alpha.
仅用于科研。不用于诊断过程。未经明确授权不得转售。
篇参考文献 (0)
生物信息学
蛋白别名: DNA repair protein XRCC1; DNA-repair protein; unnamed protein product; X-ray repair complementing defective repair in Chinese hamster cells 1; X-ray repair cross-complementing protein 1; XRCC1
基因别名: RCC; SCAR26; XRCC1
UniProt ID: (Human) P18887
Entrez Gene ID: (Human) 7515